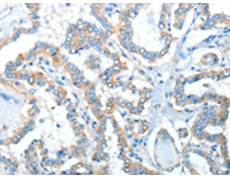
一抗

中文名稱: 兔抗ADRA1A多克隆抗體
|
Background: |
Alpha-1-adrenergic receptors (alpha-1-ARs) are members of the G protein-coupled receptor superfamily. They activate mitogenic responses and regulate growth and proliferation of many cells. There are 3 alpha-1-AR subtypes: alpha-1A, -1B and -1D, all of which signal through the Gq/11 family of G-proteins and different subtypes show different patterns of activation. This gene encodes alpha-1A-adrenergic receptor. Alternative splicing of this gene generates four transcript variants, which encode four different isoforms with distinct C-termini but having similar ligand binding properties. |
|
Applications: |
ELISA, WB, IHC |
|
Name of antibody: |
ADRA1A |
|
Immunogen: |
Synthetic peptide of human ADRA1A |
|
Full name: |
adrenoceptor alpha 1A |
|
Synonyms: |
ADRA1C; ADRA1L1; ALPHA1AAR |
|
SwissProt: |
P35348 |
|
ELISA Recommended dilution: |
1000-5000 |
|
IHC positive control: |
Human thyroid cancer |
|
IHC Recommend dilution: |
25-100 |
|
WB Predicted band size: |
51 kDa |
|
WB Positive control: |
PC3, A549 and K562 cells |
|
WB Recommended dilution: |
200-1000 |


 購物車
購物車 幫助
幫助
 021-54845833/15800441009
021-54845833/15800441009